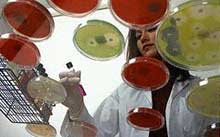

Малые венерические инфекции - бомба замедленного действия
Летний отпуск, время, когда повышен риск заразиться хламидиозом и другими, так называемыми малыми венерическими инфекциями, имеет смысл проконсультироваться у специалиста. На вопросы наших читательниц отвечает доктор медицинских наук, профессор, руководитель отдела дерматовенерологии и дерматоонкологии МОНИКИ им. М.Ф.Владимирского, заведующий кафедрой дерматовенерологии ММА им. И. М. Сеченова Владимир Алексеевич МОЛОЧКОВ.
Летний отпуск, время, когда повышен риск заразиться хламидиозом и другими, так называемыми малыми венерическими инфекциями, имеет смысл проконсультироваться у специалиста. На вопросы наших читательниц отвечает доктор медицинских наук, профессор, руководитель отдела дерматовенерологии и дерматоонкологии МОНИКИ им. М.Ф.Владимирского, заведующий кафедрой дерматовенерологии ММА им. И. М. Сеченова Владимир Алексеевич МОЛОЧКОВ.
"Я слышала, что появились новые венерические болезни, которые могут проявиться лишь через месяцы, а то и годы спустя после опасного контакта. Чем они грозят женщине?"
Светлана Миленкина, Брянская обл.
- Речь идет о "новых" венерических заболеваниях, которые оказались в фокусе внимания венерологов не так давно. К ним относятся хламидиоз, трихомониаз, бактериальный вагиноз, простой герпес и другие. Коварство этих болезней в том, что они протекают вяло и бессимптомно, мало беспокоя женщину. Однако опасность от этого не меньше.
Читайте также: Эта хитрая и коварная хламидия...
Инфекция поражает мочеиспускательный канал, шейку матки, иногда прямую кишку. Это часто приводит к осложнениям. Женщина обычно и лечит эти осложнения, например, воспаление придатков, не сознавая, что главная причина в другом. Вы можете не знать о том, что заражены, а болезнь быстро переходит в хроническую стадию. Нередко это случается уже через два месяца после заражения хламидиозом. При этом особых неприятных ощущений женщина не испытывает. 80-90 % пациенток узнают о том, что у них хламидиоз лишь тогда, когда начинают развиваться осложнения. Это могут быть воспалительные заболевания органов малого таза, бесплодие или нарушения половой функции у мужа.
Читайте также: Зачем вам ставят диагноз "хламидиоз"?
"Летом я с детьми отдыхала в отеле вместе с моей подругой, а потом выснилось, что она больна хламидиозом. Можно ли заразиться этой инфекцией через полотенце, бассейн, сауну или другие места общего пользования?"
Валентина Маргулина, Таллин
- Заражение хламидиозом через грязные руки, белье, постель или другие предметы личного пользования встречается очень редко. В быту заражение может произойти, например, через полотенце, которым только что пользовался больной, или через общую постель, если, например, девочка спала с больной мамой.
Если подобных тесных контактов не было, во время отдыха вы жили в разных номерах отеля, то беспокоиться, скорее всего, не о чем. Хотя сдать анализы все-таки стоит, чтобы убедиться в этом окончательно.
"После отпуска обнаружилось, что моя старшая дочь больна хламидиозом, причем инфекция обосновалась в носоглотке. Какие меры профилактики нужно соблюдать другим членам семьи, чтобы не заразиться?"
Ирина Коршунова, Москва
- При хламидиозе никаких особенных правил гигиены, кроме общеизвестных - тех, которые мы соблюдаем, если кто-то в семье болен ангиной, герпесом или гриппом, не существует. Выделите больной отдельное полотенце, мочалку, белье и постель. Есть она должна из отдельной посуды. Стирайте белье дочери отдельно от белья других членов семьи. Ванну необходимо чистить с применением дезинфицирующих моющих средств каждый раз после того, как ею пользовалась больная.
И не забудьте, что в первую очередь нужно проверить на наличие инфекции всех остальных членов семьи, включая детей. Это позволит принять своевременные меры и предотвратить заражение хламидиозом или развитие болезни.
"Я слышала, что сейчас в продаже появились новые антибиотики против хламидиоза, очень сильные, и с их помощью можно вылечиться самостоятельно. Какие это препараты?"
Ольга Волкова, Новгород
- Бессмысленно называть антибиотики, которые вряд ли помогут без консультации специалиста. Дело в том, что больному необходимы не только антибиотики, но и иммунотерапия, а также тщательное местное лечение. И только после такой подготовки врач назначает противомикробный препарат.
Сейчас на российский рынок стали поступать новые эффективные зарубежные препараты для лечения хламидиоза, и у некоторых пациентов, да и у докторов, возникла иллюзия, что болезнь можно вылечить только ими. Это заблуждение. Хронические стадии хламидиоза лечатся только комплексно.
"Можно ли проходить курс лечения от хламидиоза во время беременности? Не лучше ли отложить его на потом, ведь лекарства могут повредить моему будущему ребенку?"
Марина Левченко, Московская обл.
- Когда речь идет о беременной, подходы к лечению и его схема определяются гинекологом. Однако в первом триместре беременности, когда происходит закладка органов у плода, прием антибиотиков недопустим.
И все же лечить хламидиоз нужно, поскольку он очень опасен для здоровья малыша. Хламидийная инфекция может вызвать конъюнктивит новорожденных, а также бронхит и пневмонию у детей первого года жизни. Ребенок может заразиться как внутриутробно, так и при прохождении родовых путей больной матери. Если уж у вас обнаружили хламидиоз во время беременности, нужно принять меры, чтобы не заразить ребенка. Если же беременность только предполагается, нужно пройти лечение хламидиоза заранее, а беременность планировать через 4 - 6 месяцев после завершения курса.
"Мы живем в браке уже четыре года, но мне никак не удается забеременеть. Врач говорит, что мое бесплодие - результат добрачной половой жизни, хотя у меня никогда не было ни абортов, ни венерических болезней, серьезно меня ничто не беспокоит. В чем может быть причина?"
Нина Тягунова, Воронеж
- Возможно, "виноват" хламидиоз. Заражаются им от больных, не знающих о наличии у них этой болезни и отказывающихся от средств индивидуальной защиты. Так что заражение вполне могло произойти в вашей добрачной жизни. Хламидиоз долгое время специально не диагностировали и не лечили. А последствия нередко сказываются на способности женщины к зачатию и вынашиванию ребенка: этот недуг часто приводит к развитию трубного бесплодия, внематочной беременности, к невынашиванию беременности, к внутриутробному инфицированию плода.
"Подруга посоветовала лекарство от хламидиоза, но я не уверена, что у меня именно эта инфекция. По каким признакам можно самой отличить хламидиоз, например, от заражения трихомонадами?"
Дарья Новосельская, Псков
- Никаких признаков, отличающих хламидиоз от микоплазмоза или трихомониаза, практически нет. К тому же очень часто, примерно в половине случаев, все эти инфекции встречаются в сочетании. Поэтому начинать лечение нужно с анализов, устанавливающих природу заражения. И вылечиться можно только под контролем специалиста.
"Меня довольно часто мучают зуд и выделения, похожие на молочницу. Стоит ли мне еще дополнительно обратиться к венерологу или на всякий случай пропить антибиотик?"
Елена Трубникова, Москва
- Молочница может нередко сочетаться с другими инфекциями, в частности с хламидиозом. Хотя сама по себе молочница не всегда связана с заражением половым путем. Она, например, нередко возникает на фоне приема антибиотиков и некоторых других лекарств. Происходит нарушение микрофлоры влагалища, что дает шанс размножиться нетипичным бактериям. Поэтому, если есть сомнения, посетить венеролога все же стоит. Хотя вполне может оказаться, что инфекции у вас нет. А вот пить "на всякий случай" антибиотики при молочнице категорически запрещено - это может усугубить болезнетворный процесс.
"Моему мужу поставили диагноз "урогенитальный хламидиоз". Могу ли я пролечиться теми же таблетками, что прописаны ему, или надо обязательно идти к венерологу?"
Эльвира Панченко, Сочи
- Вы ни в коем случае не должны заниматься самолечением, поскольку только врач может определить, на какой стадии находится болезнь, каким спектром микробов она вызвана. Ведь хламидиоз можно лечить одними таблетками только в случае, если этот процесс свежий, давностью до двух месяцев. Такое лечение помогает, когда недуг достаточно ярко проявляет себя и ничем не осложнен. А это лишь единичные случаи. Гораздо чаще требуется комплексное лечение хламидиоза.
"Существуют ли какие-нибудь новые средства защиты от венерических инфекций?"
Жанна Любавина, Калининград
- Основной путь передачи венерических инфекций - половой. Поэтому главным профилактическим средством является презерватив. Другие средства индивидуальной защиты, такие, как мази, пасты, могут лишь снизить, но не устранить риск заражения. Любой абсолютно здоровый внешне человек может быть носителем хламидиоза. Об этом нужно помнить всегда и выбирать для себя только самое надежное средство защиты. Если же потенциально опасный контакт все-таки произошел, то женщине необходимо как можно раньше обратиться к врачу-венерологу. Сейчас в некоторых поликлиниках открылись пункты личной профилактики, можно обратиться туда.
Светлана СКВОРЦОВА
«Женское здоровье»
- Любовь без инфекций
- Симптомы проявления хламидиоза у мужчин и женщин
- Сифилис хорошо поддается лечению на первой и второй стадиях заболевания
- Анализы крови, мазок, поясничная пункция и другие методы диагностики сифилиса
- Гонорея: болезнь, разрушающая иммунитет
- Как не заразиться вирусом папилломы человека
- Что такое вирус папилломы человека
- Ошибки, увеличивающие риски заразиться ЗППП
 Здоровье
Здоровье
 Здоровье
Здоровье


Не забудьте подписаться на наш Дзен-канал!
Также наши новости в оперативном режиме в телеграм-канале.